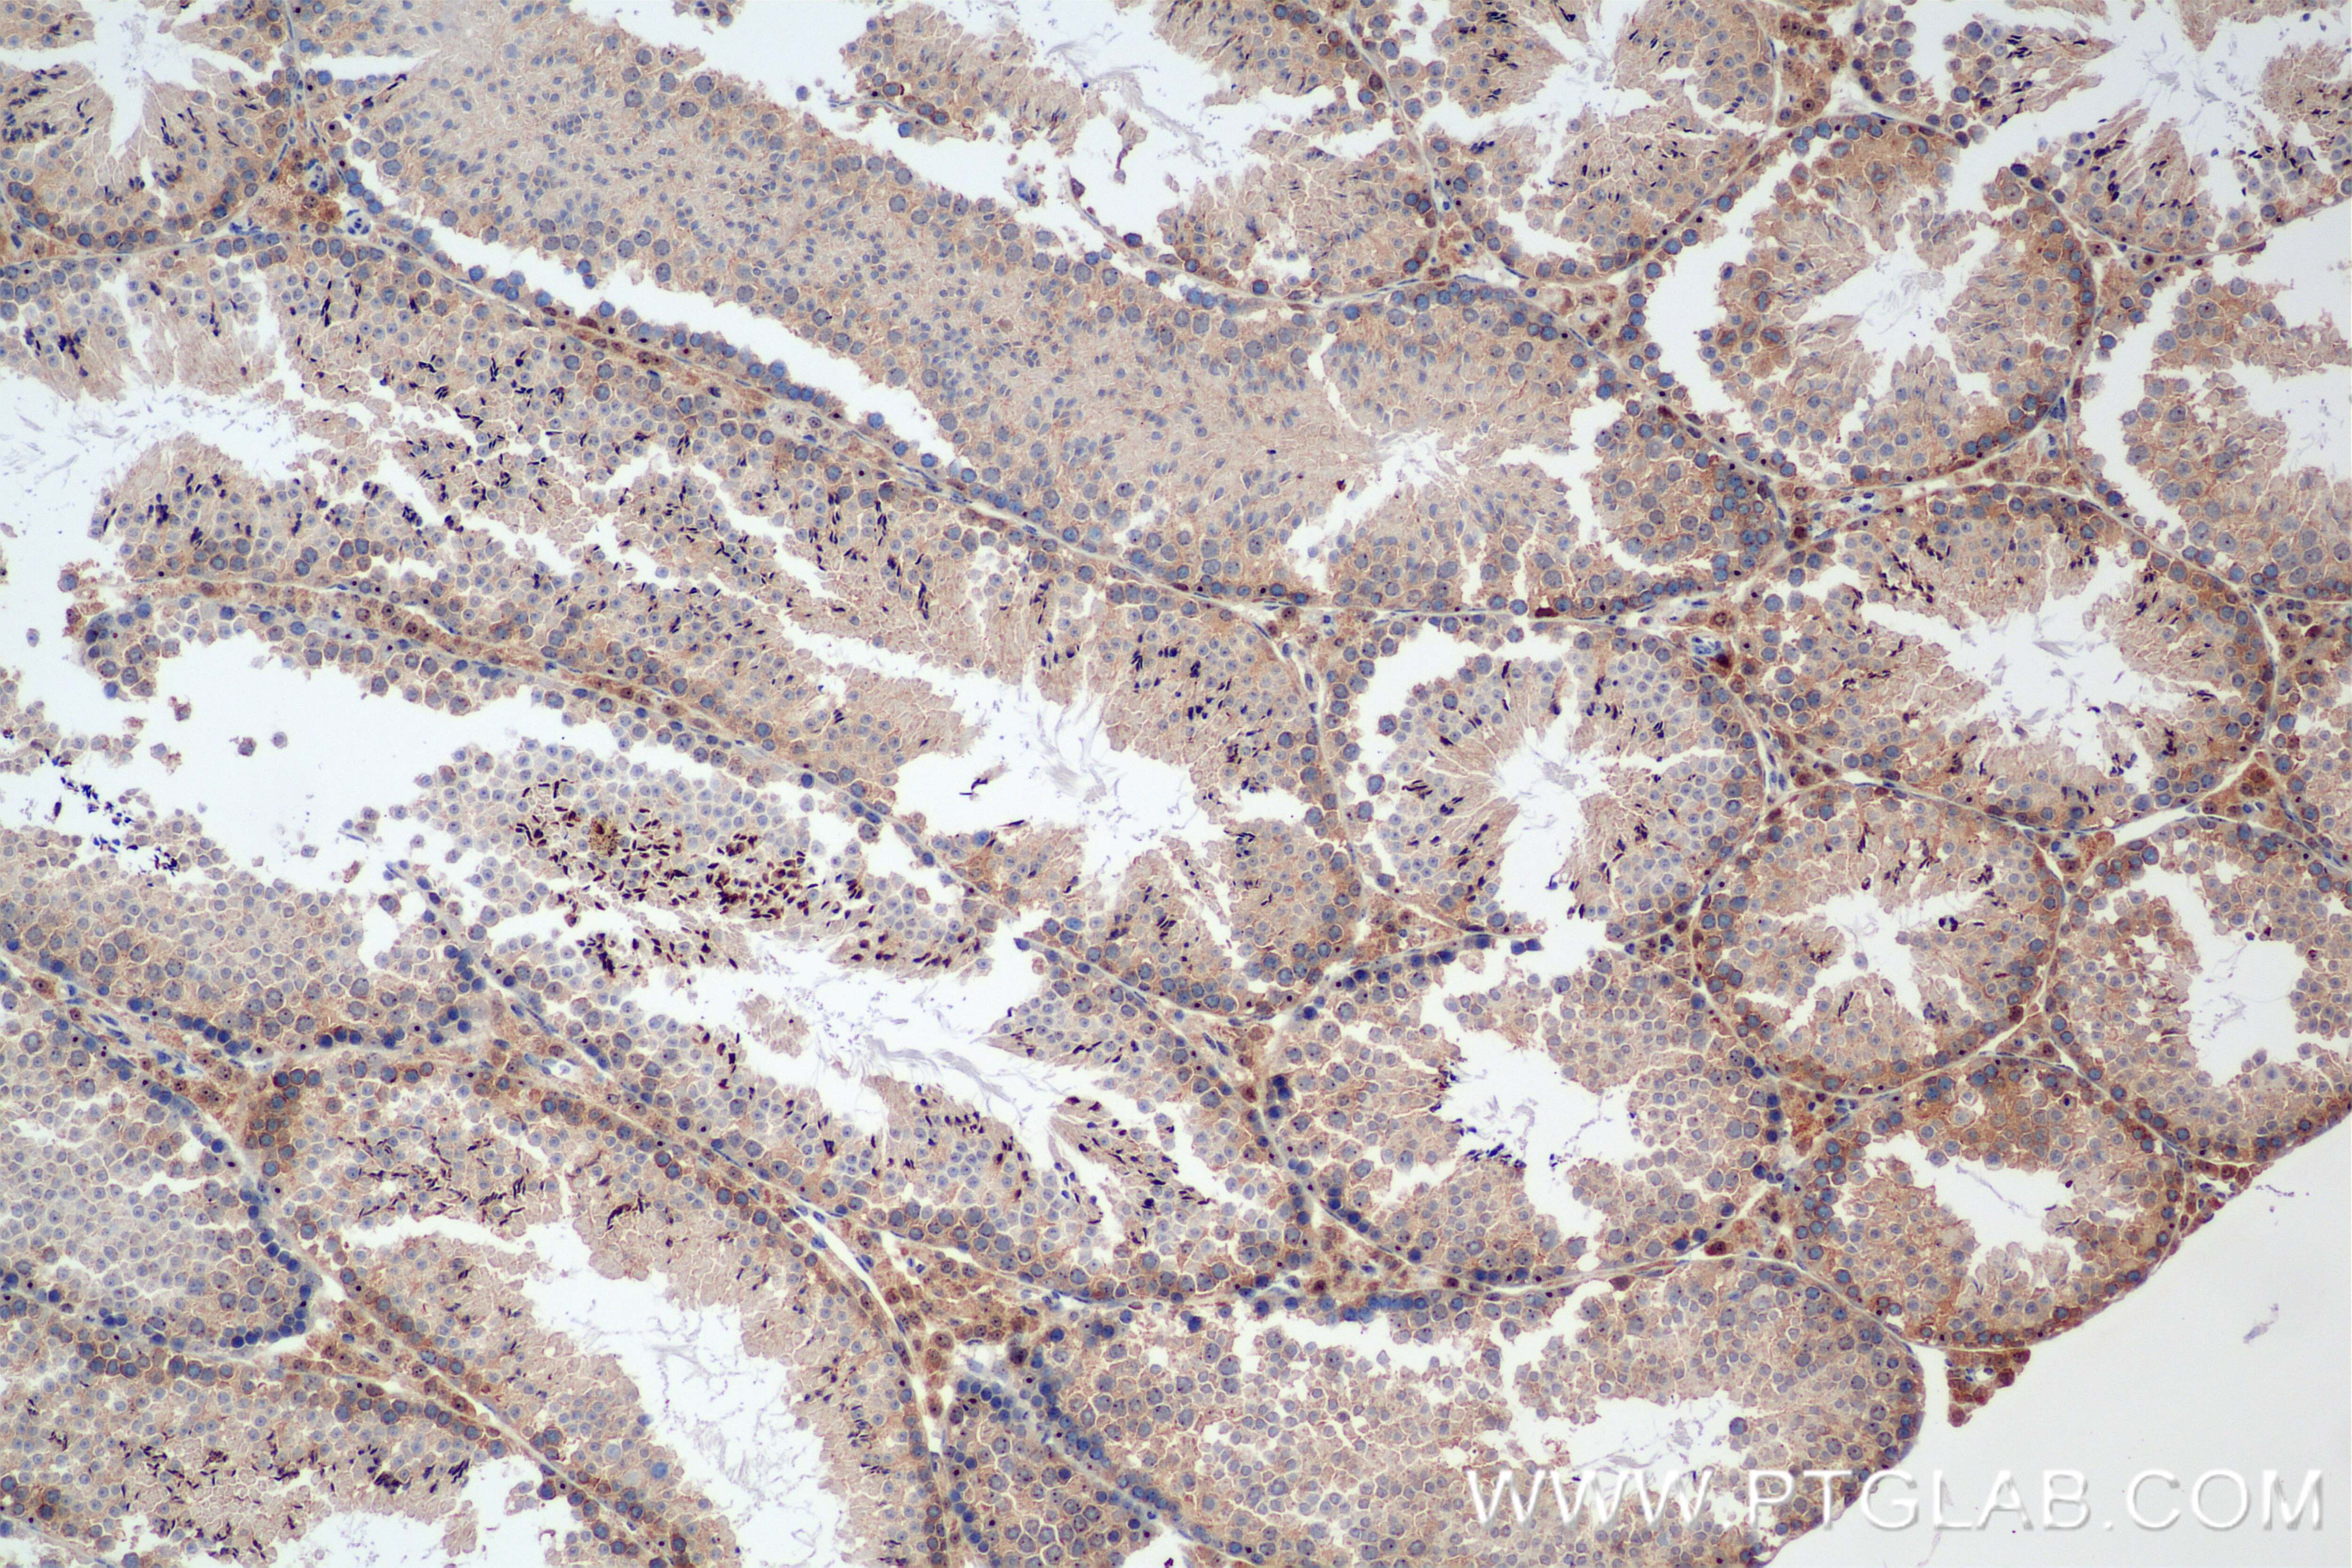
Immunohistochemistry (IHC) staining of mouse testis tissue using NRAS Recombinant monoclonal antibody (83815-2-RR)

Tested Applications
| Positive WB detected in | HeLa cells, A549 cells, HEK-293 cells, MCF-7 cells, Jurkat cells, NIH/3T3 cells, C6 cells |
| Positive IHC detected in | mouse testis tissue, mouse pancreas tissue Note: suggested antigen retrieval with TE buffer pH 9.0; (*) Alternatively, antigen retrieval may be performed with citrate buffer pH 6.0 |
Recommended dilution
| Application | Dilution |
|---|---|
| Western Blot (WB) | WB : 1:5000-1:50000 |
| Immunohistochemistry (IHC) | IHC : 1:500-1:2000 |
| It is recommended that this reagent should be titrated in each testing system to obtain optimal results. | |
| Sample-dependent, Check data in validation data gallery. | |
Product Information
83815-2-RR targets NRAS in WB, IHC, ELISA applications and shows reactivity with human, mouse, rat samples.
| Tested Reactivity | human, mouse, rat |
| Host / Isotype | Rabbit / IgG |
| Class | Recombinant |
| Type | Antibody |
| Immunogen |
CatNo: Ag1081 Product name: Recombinant human NRAS protein Source: e coli.-derived, PGEX-4T Tag: GST Domain: 1-189 aa of BC005219 Sequence: MTEYKLVVVGAGGVGKSALTIQLIQNHFVDEYDPTIEDSYRKQVVIDGETCLLDILDTAGQEEYSAMRDQYMRTGEGFLCVFAINNSKSFADINLYREQIKRVKDSDDVPMVLVGNKCDLPTRTVDTKQAHELAKSYGIPFIETSAKTRQGVEDAFYTLVREIRQYRMKKLNSSDDGTQGCMGLPCVVM Predict reactive species |
| Full Name | neuroblastoma RAS viral (v-ras) oncogene homolog |
| Calculated Molecular Weight | 21 kDa |
| Observed Molecular Weight | 21 kDa |
| GenBank Accession Number | BC005219 |
| Gene Symbol | NRAS |
| Gene ID (NCBI) | 4893 |
| Conjugate | Unconjugated |
| Form | Liquid |
| Purification Method | Protein A purification |
| UNIPROT ID | P01111 |
| Storage Buffer | PBS with 0.02% sodium azide and 50% glycerol, pH 7.3. |
| Storage Conditions | Store at -20°C. Stable for one year after shipment. Aliquoting is unnecessary for -20oC storage. 20ul sizes contain 0.1% BSA. |
Background Information
NRAS, also named as N-ras and NRAS1, is neuroblastoma RAS viral (v-ras) oncogene homolog from the mammalian ras gene family and it is a member of the small GTPase superfamily. RAS proteins are involved in signal transduction pathways, and bind GDP/GTP and possess intrinsic GTPase activity. It is mapped on chromosome 1, and it is activated in HL60, a promyelocytic leukemia line. Defects in NRAS are a cause of juvenile myelomonocytic leukemia (JMML). NRAS is one member of RAS gene family of oncoproteins, which is commonly mutated in melanoma and hematopoietic cancers via mapped on chromosome 1 (PMID: 2327491, PMID: 26990546). NRAS mediates activation of both mitogen-activated protein kinase (MAPK) and PI3K/AKT/MYC signaling (PMID: 17297468). NRAS induced classical MAPK signaling leads to cyclin D1 expression and cell cycle dysregulation and promotion of prosurvival pathways (PMID:7970723,PMID: 18246127). In addition, NRAS effectively prevents Glycogen Synthase Kinase3 (GSK3)-mediated phosphorylation of MYC via PI3K/AKT, which results in enhanced activity of endogenous MYC protein (PMID: 17297468). Mutational NRAS causes Ras-GTP to be in a state of continuous activation, which results in malignant proliferation and metastasis (PMID: 24985059).
Protocols
| Product Specific Protocols | |
|---|---|
| IHC protocol for NRAS antibody 83815-2-RR | Download protocol |
| WB protocol for NRAS antibody 83815-2-RR | Download protocol |
| Standard Protocols | |
|---|---|
| Click here to view our Standard Protocols |